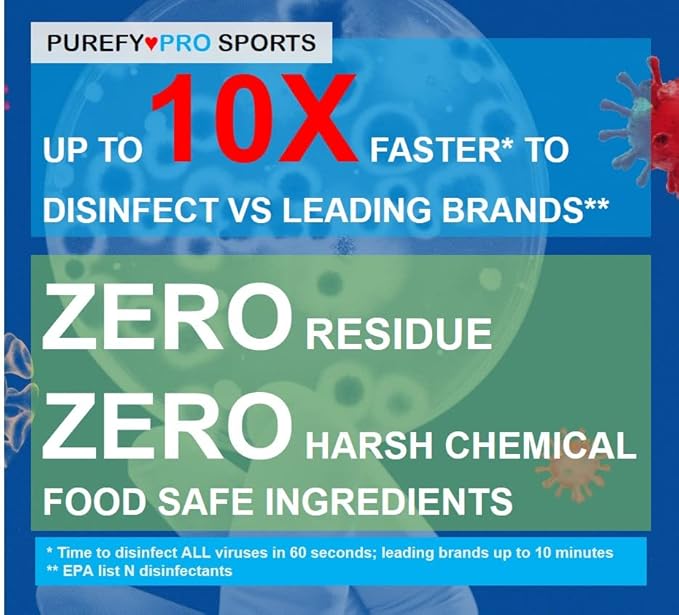
Purefypro Sports Equipment Disinfectant Spray (16oz, 2pk) Kills 99.9999% MRSA, HIV, Athlete Foot Fungus, Virus, Fungi. No Residue. Great For Sports Pads, Yoga Mats, Shoes, Boxing Gloves, Gym Equipment

PUREFYLIFE
Purefypro Sports Equipment Disinfectant Spray (16oz, 2pk) Kills 99.9999% MRSA, HIV, Athlete Foot Fungus, Virus, Fungi. No Residue. Great For Sports Pads, Yoga Mats, Shoes, Boxing Gloves, Gym Equipment
Purefypro Sports Equipment Disinfectant Spray (16oz, 2pk) Kills 99.9999% MRSA, HIV, Athlete Foot Fungus, Virus, Fungi. No Residue. Great For Sports Pads, Yoga Mats, Shoes, Boxing Gloves, Gym Equipment
Couldn't load pickup availability
About This
- HEALTHIER: Kills drug resistant MRSA, VRE and fungus, Kills Norovirus, HIV (Aids virus) and Influenza, Norovirus, Hepatitis in as short as 60 seconds. Prevents growth of damaging mold and mildew. Eliminates odors and allergens.
- PURER: Free of alcohol, synthetic fragrance, and VOC; No harsh chemical residue (turns into water)
- SAFER: Noncorrosive, pH balanced; Safe for sensitive materials like rubber gym mat use; Recommended by doctors for sensitive population including allergic asthma, atopic dermatitis (eczema), immunodeficient etc.
- PROVEN: Proven by hospitals, senior care, and childcare facilities to protect those most vulnerable from germs, allergens, and contaminants.
Overview
- Brand : PUREFY
- Item Form : Liquid
- Item Weight : 16 Ounces
- Material Type Free : Alcohol Free, Synthetic Fragrance Free, VOC Free
- Number of Items : 1